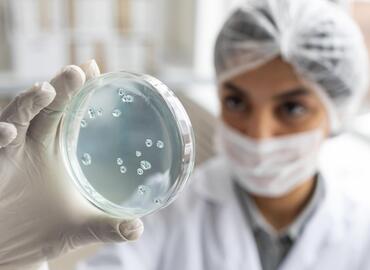
Mikrobiyoloji Neye Bakar?

- İnönü Mahallesi Batı Bulvarı No:99 Batıkent / Yenimahalle / Ankara
-
 0 (312) 278 37 37
Dil Seçin:
0 (312) 278 37 37
Dil Seçin:
Klinik Mikrobiyoloji
 Hastanemizin Klinik Mikrobiyoloji Laboratuvarı, polikliniğe başvuran her yaş grubundan hastaların yanı sıra özellikle yoğun bakım ve kadın doğum klinikleri ağırlıklı olmak üzere çok geniş bir hasta yelpazesine hizmet sunmaktadır.
Hastanemizin Klinik Mikrobiyoloji Laboratuvarı, polikliniğe başvuran her yaş grubundan hastaların yanı sıra özellikle yoğun bakım ve kadın doğum klinikleri ağırlıklı olmak üzere çok geniş bir hasta yelpazesine hizmet sunmaktadır.Cihazlarımız güncel teknolojiye uygun olup, düzenli ve sürekli bakım ve kalibrasyon ölçümlerinin yapılması sağlanarak optimal koşullarda çalışması sağlanmaktadır.
Laboratuvarımızda yapılan testler;
BAKTERİYOLOJİ ve PARAZİTOLOJİ
Klinik örneklerden rutin bakteriyolojik kültürlerle izole edilen etkenlerin otomasyon sistemi ile identifikasyon ve antibiyogramları,
· Tüberküloz kültürü
· Kan kültürü
· Hızlı antijen testleri (Strep A, Rotavirüs, Helicobacter Clostridium difficile toksini, Chlamidya gibi.. )
· Dışkıda parazit incelemesi
· Salmonella ve Brucella için serolojik testler
· Mycoplasma ve Ureaplasma tanıları, duyarlılık testleri
· Mantar identifikasyon ve duyarlılık testleri
İMMÜNOLOJİ
· Nefelometrik yöntemle kantitatif CRP, ASO, RF, Ig alt grupları .
· Fluoresans mikroskobunda IFA yöntemi ile ANA, anti dsDNA gibi otoantikorların tayini
SEROLOJİ
· MEIA yöntemiyle hepatit markerleri, HIV antikorlarının tayini
· ELFA yöntemiyle TORCH grubu antikorların tayini
· Spesifik IgE